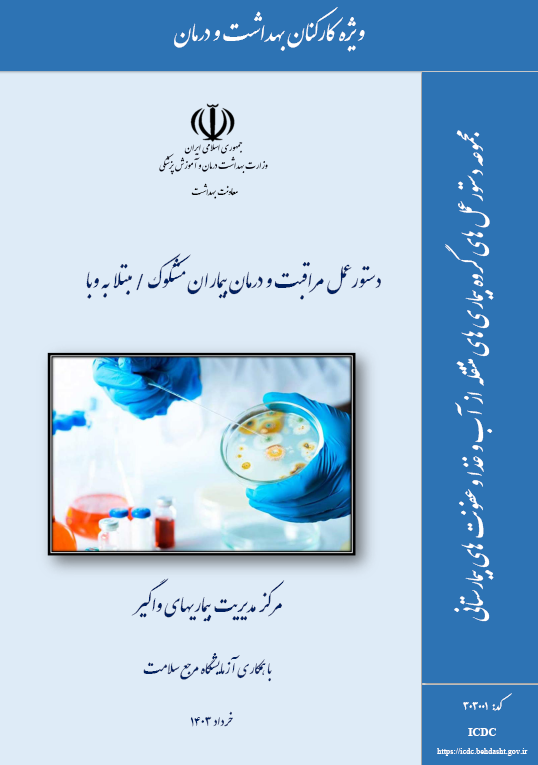

دستورالعملهای ایدز و بیماری های آمیزشی |
دستورالعملهای سل و جذام |
دستورالعملهای بیماریهای منتقله از آب و غذا |
دستورالعملهای کنترل عفونتهای بیمارستانی |
دستورالعملهای ایمنسازی و بیماریهای قابل پیشگیری با واکسن |
| افراد آنلاین | 0 |
| بازدید صفحه جاری | 5 |
| تاریخ بروز رسانی | 1404/06/22 |
| بازدید امروز | 254 |
| بازدید دیروز | 1406 |
| بازدید کل | 128292 |